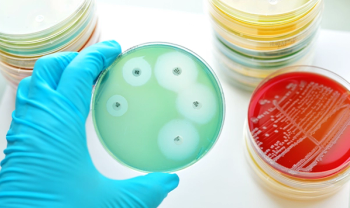
antibiotic resistance testing on Petri dish

Lawrence Maida, proprietor, pharmacist in charge, Maida Pharmacy and Compounding Center, discusses some of the reasons why compounding is vital for keeping healthcare personal.

Lawrence Maida, proprietor, pharmacist in charge, Maida Pharmacy and Compounding Center, discusses some of the reasons why compounding is vital for keeping healthcare personal.

Fred Gebhart, Drug Topics contributing editor, lays out the history of compounding and introduces three experts in the pharmaceutical compounding field.

Derived from cultured adult bone marrow-derived mesenchymal stem cells that have undergone temporary genetic modification.

Ensuring your pharmacy’s video marketing dusts the competition has never been more important.


Monoclonal antibody shows potential for lupus nephritis treatment.
Programs shown to improve patient outcomes, reduce antibiotic resistance, and decrease healthcare costs.


23,600 cases across 29 states since 2016.

Combination therapy for advance endometrial carcinoma.

Fear, one's faith in the government, and likelihood of exposure are leading factors.

Oncologists recognize the potential of artificial intelligence (AI) in improving the quality of care and patient outcomes according to new research.

Indicated as part of a three-drug oral combination.

The 2018 oncology drug market had a record number of new treatments and continued a trend of growth.

NHE3 inhibitor administered as 50 mg oral tablets.

New medications and treatment guidelines

Patients are still allowed to take medicines as prescribed.

Fentanyl, oxymorphone, and hydrocodone face greatest cuts.

"Community pharmacies have reasons to be optimistic..." writes Jhaveri.

Eight pharmacy groups lauded a letter urging the Trump administration to reform direct and indirect remuneration (DIR) fees.

Current phase 3 studies investigative novel, preventative approaches.

Investigational oral MET kinase inhibitor from Merck.

The age indication for some influenza vaccines has been expanded.

New changes are making it more difficult for generics and biosimilars to compete on formularies.

Technicians, clerks, even front-end cashiers are taking on new responsibilities.


Oral supplements for metabolic disorder.

Oral kinase inhibitor for SSc-ILD.

First generic specialty injections approved for Novadoz Pharmaceuticals.